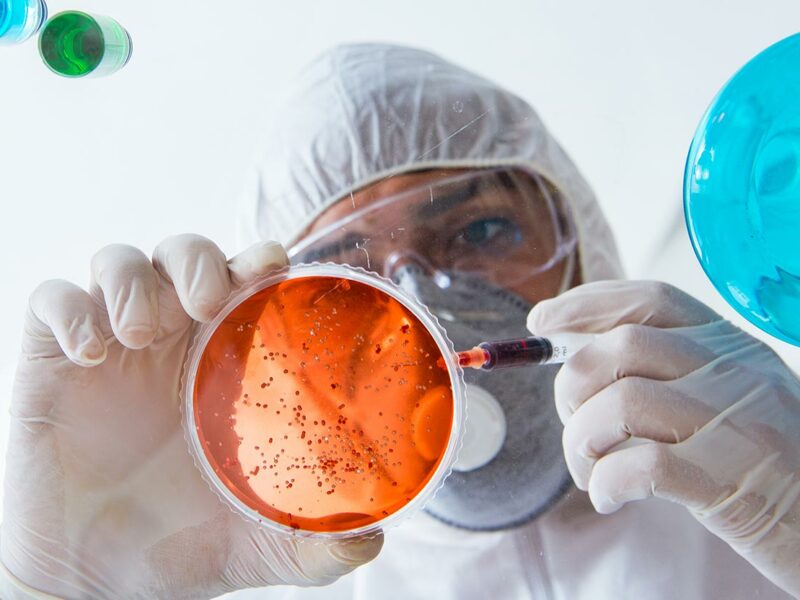
m

Referentes en Estudios de Genómica Molecular. Ofrecemos asesoría personalizada en Enfermedades Genéticas.
Contamos con una amplia gama de servicios y pruebas de análisis molecular y seguimos creciendo con tecnologías de última generación, es por eso que todas nuestras pruebas son analizadas en nuestras instalaciones, evitando los riesgos que implica el envío de muestras fuera del estado.